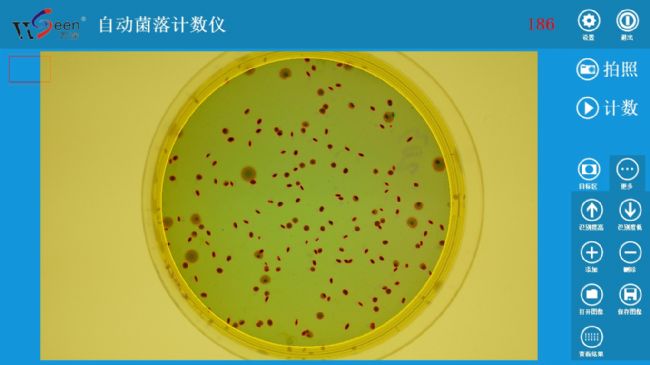

- 杭州萬深檢測科技有限公司
- 地址:杭州市西湖區(qū)文二西路11號嘉樂金座418室
- 聯(lián)系人:周先生
- 電話:0571-89714590,81387570
- 官網(wǎng):http://www.wseen.com
產(chǎn)品詳情
HiCC-B1型Ai智能全自動菌落計數(shù)儀
一、用途
用于微生物、菌落總數(shù)的自動計數(shù)分析,快速、有效替代半自動計數(shù)菌落的落后工作方式。
二、主要技術指標
1、★配自動對焦的大景深800萬像素(3264x2448像素)彩色拍攝主機,具有微距拍攝特性。全封閉暗箱以消除環(huán)境雜散光干擾。任意調柔性無影光的上光源,下光源、上下雙光源,5W大功率的275nm+395nm雙波長紫外光照明(用于腔體消毒、紫外誘變),可自由組合和任意獨立切換,以構成清晰的懸浮暗視野菌落成像效果,突顯出菌落形態(tài),獲得最佳菌落成像,實現(xiàn)傻瓜式智能識別計數(shù)。
2、適應培養(yǎng)皿:50~130mm(傾注、膜濾、3M紙片)。
3、★對無蔓延菌落生長、菌落數(shù)300CFU以內的平板,一鍵拍照Ai智能自動計數(shù)精度≥98%(對標準菌株的計數(shù)精度達99.3%以上),極少修正即達100%正確。分析速度:50~500個菌落/s(計數(shù)分析耗時1~4秒)。對顯色培養(yǎng)基培養(yǎng)出來的大腸桿菌群也能有效自動計數(shù)??勺詣幼R別計數(shù)≥0.1mm的菌落。
4、自動分割鏈狀或團狀粘連的各類菌落,符合菌落總數(shù)計數(shù)國標要求。
5、自動剔除雜質,觸屏縮放圖像和點擊修正等前衛(wèi)操作,有效支持復雜微生物統(tǒng)計。
6、可存上萬張圖片及其對應的數(shù)據(jù),并無線上網(wǎng)來遠程發(fā)送圖片、結果數(shù)據(jù)。
三、標準配置
1、HiCC-B1型Ai智能全自動菌落計數(shù)儀軟件U盤及軟件鎖1套
2、自動對焦的大景深800萬像素彩色拍攝主機1臺
3、品牌電腦(14代酷睿i5 CPU / 16G內存/ 23.5”彩顯/無線網(wǎng)卡,1個USB3.0+1個USB2.0口,運行環(huán)境Windows 10或11完整專業(yè)版)1臺
備注:
本技術標書中打★款項必須響應,否則為重大偏離
WSeen’s HiCC-B1 automatic colony counter
Overview:
WSeen’s HiCC-B1 automatic colonies counter for the PC, automatic colony counting software, backlight imaging device. Mainly used for micro-organisms, the total count of the automatic count analysis, rapid and effective alternative to manual or semi-automatic counting of colony lagging work.
Features:
1, by a PC, the software will automatically count and output the number of colonies with Ai support.
2, by adding, deleting the individual pointing correction, can make a few grains up to 100% accuracy.
3, can view the results table, export to EXCEL, and to the designated recipient to upload data.
4, highlight LED backlight device to colony count recognition more stable, can work long hours.
5, Windows system environment, user-friendly, concise, intelligent.
Technical Parameters:
1, with a color 800 megapixel autofocus camera, the highest resolution of 0.05mm, can identify as small as 0.1mm colony
2, suspended dark field of vision, the backlight can be switched imaging analysis of ultra-thin imaging device
3, to adapt Petri dishes diameter: 50 ~140mm plate (pouring, membrane filtration, 3M paper)
4, automatic segmentation of chain or lumps of various types of colonies adhesion
5, automatic counting accuracy ≥ 98%, with very few amendments up to 100% correct. Analysis speed: 50 - 300 colonies / s
5, automatic removal of impurities, click on the touch screen correction, effective support for complex microbiological statistics
6, can save tens of thousands of pictures and their corresponding data, and wireless Internet to send pictures remotely, the result data
Availability list:
a LED imaging device with 800 megapixel color camera and a power adapter (for AC220V), a software lock (under windows 10 Professional edition) and a software U disk, a dark field of a black film
其具有全英文版,已多批次出口國外并有效使用。
注:本技術標書中打★款項必須響應,否則為重大偏離

應用萬深系列考種儀、植物圖像分析儀器在國內外高端學術刊物上發(fā)表的部分學術論文已逾1306篇:http://www.wseen.com/News.aspx?id=6
有老師用萬深系統(tǒng)來高效率實驗,在Nature上發(fā)表的論文影響因子(IMF)有40多(Huang, X. et al. Genomic analysis of hybrid rice varieties reveals numerous superior alleles that contribute to heterosis. Nat. Commun. 6:6258 doi: 10.1038/ncomms7258 (2015).)。
萬深www.wseen.com商務電話0571-89714590,81387570,找小王QQ1319487103、小張QQ3027303769、小黃QQ3506624085



